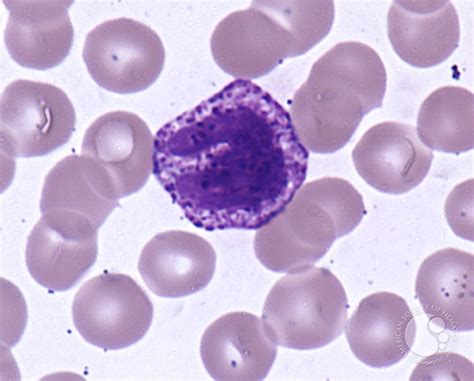

Unraveling Equine Allergies: Understanding the Role of Basophils in Horse Allergies
- firstchoiceequine

- May 17, 2024
- 3 min read
Horses, majestic creatures of strength and grace, are not immune to the woes of allergies. Much like humans, they can suffer from various allergic reactions, which can manifest in different ways. One intriguing aspect of equine allergies is the role of basophils, a type of white blood cell, in indicating allergic reactions, particularly to horses themselves. In this blog, we delve into the fascinating connection between high basophils and horse allergies, shedding light on why these indicators matter in equine health.
Understanding Basophils: Basophils are a type of white blood cell primarily involved in allergic responses and inflammation. They contain granules filled with histamine and other chemicals that are released when the immune system encounters an allergen. This release of histamine triggers the symptoms commonly associated with allergic reactions, such as itching, swelling, and inflammation.
Basophils play a crucial role in the body's immune response by helping to identify and neutralize foreign substances, but they can also contribute to hypersensitivity reactions when the immune system overreacts to harmless substances, such as pollen, dust, or certain proteins.
Horse Allergies: Horses, like humans and other animals, can develop allergies to a variety of substances. These allergies can be triggered by environmental factors, such as pollen or dust mites, or by specific proteins found in their diet or surroundings. However, one lesser-known aspect of equine allergies is the potential for horses to be allergic to other horses.
Horse allergies to other horses, known as "horses being allergic to horses," may sound peculiar, but it's a documented phenomenon. These allergies can be directed towards proteins found in horse dander, saliva, or even specific proteins in the skin or hair. When a horse is allergic to other horses, it can lead to a range of symptoms, including itching, hives, respiratory distress, and even behavioral changes.
The Role of Basophils in Horse Allergies: When a horse is exposed to an allergen, whether it's pollen, dust, or proteins from other horses, its immune system kicks into gear. Basophils, among other immune cells, are recruited to the site of the allergic reaction. In cases of horse allergies, where the allergen is another horse or substances associated with horses, basophils may play a significant role in the body's response.
Research suggests that horses allergic to other horses may have elevated levels of basophils in their blood when exposed to the allergen. This increase in basophils reflects the immune system's heightened response to the perceived threat, leading to the release of histamine and other inflammatory mediators. As a result, horses may exhibit allergic symptoms such as itching, swelling, and respiratory issues.
Detecting Horse Allergies: Diagnosing allergies in horses can be challenging, as the symptoms may overlap with other health conditions. However, veterinarians can perform various diagnostic tests to identify the specific allergens triggering a horse's allergic reactions. These tests may include skin prick tests, blood tests for specific antibodies (such as IgE), or even intradermal tests.
Additionally, monitoring basophil levels in a horse's blood can provide valuable insights into its allergic status. While elevated basophils alone may not confirm a diagnosis of horse allergies, they can serve as an important indicator, especially when correlated with clinical signs and other diagnostic findings.
Management and Treatment: Managing horse allergies typically involves minimizing exposure to the allergen whenever possible and providing symptomatic relief for affected horses. This may include implementing environmental controls to reduce exposure to allergens, such as keeping horses stabled indoors during high pollen seasons or using allergen-proof bedding.
In cases where avoidance is not feasible or sufficient, veterinarians may recommend allergy desensitization therapy, also known as immunotherapy. This treatment involves gradually exposing the horse to small, controlled doses of the allergen, with the goal of desensitizing the immune system and reducing the severity of allergic reactions over time.
Conclusion: Horse allergies, including allergies to other horses, are a complex and often misunderstood aspect of equine health. The role of basophils in indicating allergic reactions in horses, particularly to horse-related allergens, highlights the intricate interplay between the immune system and allergic responses in these magnificent animals.
By understanding how basophils function in the context of horse allergies, veterinarians and horse owners can better diagnose, manage, and treat allergic conditions in horses, ultimately improving the health and well-being of these beloved animals.
CLICK HERE to check out Cromolyn Sodium Nebulizer Solution
%20(1).png)

Comments